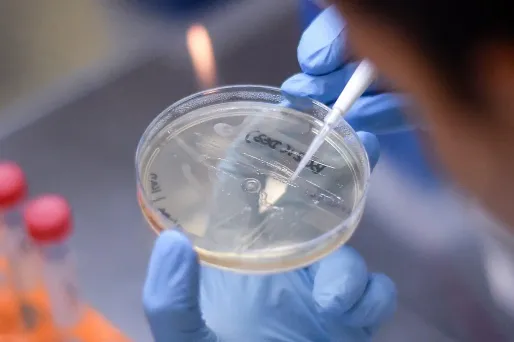
L'UE va organiser une conférence des donateurs en ligne le 4 mai afin de lever des fonds pour la recherche d'un vaccin.

Vaccin contre le coronavirus : l'UE organise une conférence des donateurs le 4 mai
La présidente de la Commission européenne, Ursula von der Leyen, a annoncé mercredi la tenue le 4 mai d'une conférence des donateurs en ligne afin de lever de fonds pour la recherche d'un vaccin et de traitements contre le coronavirus.
La présidente de la Commission européenne, Ursula von der Leyen, va organiser une conférence des donateurs en ligne le 4 mai afin de lever des fonds pour la recherche d'un vaccin et de traitements contre le nouveau coronavirus , a-t-elle annoncé mercredi.
Un vaccin est "notre meilleure chance collective de vaincre le virus", a expliqué Mme von der Leyen lors d'une conférence de presse. La conférence "permettra d'aborder la question des déficits de financement immédiats et de trouver des solutions innovantes et équitables", a-t-elle ajouté.





